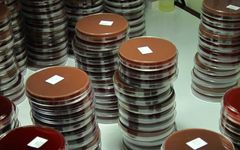
Nenänielunäytteitä Maelan pakolaisleiriltä. Kukin rasia (kasvatusmalja) sisältää yksittäisen näytteen viljelyn tuloksen eli bakteerikasvuston.

Vieläkö antibiootit tehoavat lasten korvatulehduksiin?
31.10.2025 12:21:03 EET | Helsingin yliopisto | Tiedote
Keuhkokuumetta ja lasten välikorvantulehdusta aiheuttavan bakteerin geneettistä vaihtelua kartoittanut tutkimus toi lisävalaistusta bakteerin leviämiseen ja kehittymiseen.

Uusi tutkimus paljastaa Haemophilus influenzae -bakteerin ripeän leviämisvauhdin ja antibioottiresistenssin laajuuden maailmanlaajuisesti. Haemophilus influenzae on merkittävä bakteeripatogeeni, joka aiheuttaa sekä mm. aivokalvontulehdusta ja keuhkokuumetta sekä välikorvantulehdusta.
Maailmanlaajuisesti arvioidaan olevan yli 700 miljoonaa välikorvantulehdustapausta vuosittain, ja H. influenzae aiheuttaa niistä noin neljänneksen. Välikorvantulehdus on yleisin syy antibioottien määräämiseen pienille lapsille.
Helsingin yliopiston ja Oslon yliopiston professori Jukka Corander johti hanketta Cambridgessa sijaitsevassa Sanger Instituutissa, jossa hän on työskennellyt bakteerigenomiikan parissa jo lähes kuusi vuotta.
Se on ensimmäinen laajamittainen H. influenzaen perimän kartoitustutkimus, ja edistää merkittävästi lajin epidemiologian ja evoluution ymmärtämistä. H. influenzae oli ensimmäinen bakteeri, jonka perimä eli genomi selvitettiin kokonaisuudessaan yhdestä näytteestä ja tämän julkaisu vuonna 1995 sysäsi liikkeelle uuden aikakauden mikrobiologiassa. Silloin yhden ainoan bakteerigenomin ”lukeminen” eli sekvensointi vei käytännössä vuosia, mutta nykyisellä teknologialla pystytään kartoittamaan jopa tuhansia genomeja muutamassa kuukaudessa, mikäli käytössä on tarpeeksi resursseja.
Tämä ensimmäinen tutkimus, jossa H. influenzae -bakteeria tutkitaan kattavasti köyhissä ja kehittyvissä maissa käyttäen tarkkaa genomien vaihtelun kartoitusta.
–Sekvensoimme noin 4 500 eristettyä bakteeria Thaimaan koillisosassa sijaitsevan Maelan pakolaisleirin lapsilta ja yhdistimme nämä tiedot kaikkiin julkisesti saatavilla oleviin H. influenzae -genomeihin, joista löytyi tarvittavat taustatiedot, kuten paikka ja aika, kertoo Corander.
Tutkimuksen genominen vaihe kesti yli 7 vuotta, laskien siitä, kun tutkijat alkoivat valmistella pakastimeen säilöttyjä bakteerinäytteitä sekvensointia varten. Analyysit vaativat populaatiogenomiikan ja bioinformatiikan erityisasiantuntemusta sekä valtavaa laskenta- sekä tallennuskapasiteettia.
–Näin laajamittainen perustutkimus ei olisi ollut mahdollista ilman pitkäjänteistä rahoitusta, toteaa Corander.
Tutkijat havaitsivat, että laajakirjoinen antibioottiresistenssi (MDR) oli yleistä Maelan näytteissä ja että se on kehittynyt ja levinnyt usein rekombinaation kautta, missä eri bakteerikannat vaihtavat perimää keskenään, kun ne päätyvät kolonisoimaan saman ihmisen.
Havaitut antibiooteille vastustuskykyiset kannat ovat levinneet maailmanlaajuisesti ja saattavat jo olla yleisiä alueilla, joilla tämän bakteerin aiheuttamia tauteja esiintyy paljon. Lisäksi tutkijat havaitsivat, että niin sanotut tyypittömät (NT) H. influenzae -kannat olivat yleisimpiä keuhkokuumetapauksissa Maelan väestössä, vaikka he eivät olleet saaneet Hib-rokotetta joka suojaa b tyypin H. influenzae kantajuutta ja tautia vastaan.
Keuhkokuumepotilaiden ja terveiden kantajien välillä ei havaittu geneettisiä eroja NT H. influenzae bakteereissa, mikä viittaa siihen, että kaikilla NT-kannoilla on yhtäläinen kyky aiheuttaa vakavia tauteja, kuten keuhkokuumetta.
Laajojen analyysien perusteella paljastui, että tämän bakteerilajin nopea alueellinen ja mannertenvälinen leviäminen on yleistä, ja että niiden genomit rekombinoivat keskenään hyvin usein. Tämä on johtanut siihen, että lajilta puuttuu tietylle maantieteelliselle alueelle tai ajanjaksolle tyypillinen geneettinen vaihtelu, ja se eroaa tässä suhteessa merkittävästi muista yleisesti hengitystieinfektioita aiheuttavista bakteereista kuten meningokokeista ja pneumokokeista.
Suositukset jatkotoimenpiteiksi:
- Maailman terveysjärjestö on vuonna 2024 päivitetyssä antibioottiresistenssin priorisointilistassa luokitellut H. influenzae bakteerin keskivaiheen priorisointiryhmään. Nyt saatujen tietojen valossa pitäisi harkita MDR kantojen siirtämistä korkeampaan riskiluokitukseen.
- WHO on myös äskettäin sisällyttänyt H. influenzae bakteerin päivitettyyn GLASS antibioottiresistenssin seurantajärjestelmään perustuen hengitystienäytteisiin. Tämä on erittäin tärkeä edistysaskel mutta koska GLASS järjestelmän maantieteellinen kattavuus on rajattu, olisi toivottavaa saada vastaavanlainen seuranta lisäksi laajemmin käyttöön eri maiden omissa kansanterveysinstituuteissa. .
- Rutiininomainen seuranta sekä terveestä kolonisaatiosta että tautitapauksista perustuen näytteiden genomin kartoitukseen auttaisi paremmin arvioimaan resistenssin leviämisen laajuutta ja reittejä.
Hib-rokote on otettu käyttöön useimpien maiden kansallisissa rokotusohjelmissa ja se on erittäin tehokas Hib-kolonisaatiota ja -tautia vastaan, mutta ei suojaa NT-kantoja tai muita serotyyppejä vastaan
Tämä tutkimus antaa lisäpontta yleisen rokotteen kehittämiselle H. influenzae -bakteeria vastaan, jotta tämän lajin aiheuttamaa tautitaakkaa ja terveyshaittoja voitaisiin merkittävästi vähentää maailmanlaajuisesti. Corander pyrkiikin parhaillaan hankkimaan rahoitusta tämänkaltaisen rokotteen varhaisen vaiheen tutkimusta varten.
Lähde: Genetic population structure of Haemophilus influenzae at local and global scales, Neil MacAlasdair et.al. 2025, Nature Microbiology https://www.nature.com/articles/s41564-025-02171-9
Lisätietoja:
Jukka Corander, jukka.corander@helsinki.fi, +358 504155294 (31.10.2025 tavoitettavissa numerosta +4748049047)
Yhteyshenkilöt
Helsingin yliopiston mediapalvelu
Puh:02941 22622mediapalvelu@helsinki.fiRiitta-Leena InkiViestinnän asiantuntija
Puh:+358 50 448 5770riitta-leena.inki@helsinki.fiKuvat
Linkit
Tietoja julkaisijasta
Helsingin yliopisto on yli 40 000 opiskelijan ja työntekijän kansainvälinen yhteisö, joka tuottaa tieteen voimalla kestävää tulevaisuutta koko maailman parhaaksi. Se sijoittuu kansainvälisissä yliopistovertailuissa maailman sadan parhaan yliopiston joukkoon. Monitieteinen yliopisto toimii neljällä kampuksella Helsingissä sekä Lahden, Mikkelin ja Seinäjoen yliopistokeskuksissa. Lisäksi sillä on kuusi tutkimusasemaa eri puolilla Suomea ja yksi Keniassa. Yliopisto on perustettu vuonna 1640.
Tilaa tiedotteet sähköpostiisi
Haluatko tietää asioista ensimmäisten joukossa? Kun tilaat tiedotteemme, saat ne sähköpostiisi välittömästi julkaisuhetkellä. Tilauksen voit halutessasi perua milloin tahansa.
Lue lisää julkaisijalta Helsingin yliopisto
Puun pintakäsittely saattaa hillitä haitallisten bakteerien kasvua12.3.2026 11:00:00 EET | Tiedote
Tuoreen tutkimuksen mukaan bakteerit menestyvät paremmin käsittelemättömillä kuin käsitellyillä puupinnoilla. Tällä on merkitystä kodin ja julkisten tilojen hygienian kannalta.
Automaatio tehostaa lääkkeiden potilaskohtaista jakoa ja parantaa potilasturvallisuutta11.3.2026 12:44:06 EET | Tiedote
Sairaaloiden lääkkeiden jakoprosessien automatisointi voi merkittävästi parantaa potilasturvallisuutta ja tehostaa työnkulkuja. Uudet teknologiat vaativat kuitenkin harkittua käyttöönottoa.
Sateenkaarinuorten kokemukset mielenterveyspalveluista tuovat esiin merkittäviä puutteita9.3.2026 08:30:00 EET | Tiedote
Ongelmalliset kohtaamiset liittyivät erityisesti cisheteronormatiivisiin oletuksiin, ammattilaisten puutteelliseen osaamiseen sekä siihen, että nuoret joutuivat itse kouluttamaan ammattilaisia sukupuolen ja seksuaalisuuden moninaisuudesta.
KUTSU 18.3.: Urheilijan hyvinvointi, kaltoinkohtelu ja oikeusturva -hankkeen päätöstilaisuus4.3.2026 08:15:00 EET | Kutsu
Tutkimushankkeessa julkaistaan nyt tulokset, jotka perustuvat laajaan, yli 3 600 urheilijan kyselyyn ja erillisiin haastatteluihin.
Väitös: Monipaikkaisten asukkaiden mahdollisuuksia ei osata hyödyntää3.3.2026 12:21:15 EET | Tiedote
Monipaikkainen asuminen voi helpottaa epätasaisen aluekehityksen aiheuttamia haasteita vapaa-ajanasukasvaltaisella maaseudulla.
Uutishuoneessa voit lukea tiedotteitamme ja muuta julkaisemaamme materiaalia. Löydät sieltä niin yhteyshenkilöidemme tiedot kuin vapaasti julkaistavissa olevia kuvia ja videoita. Uutishuoneessa voit nähdä myös sosiaalisen median sisältöjä. Kaikki tiedotepalvelussa julkaistu materiaali on vapaasti median käytettävissä.
Tutustu uutishuoneeseemme